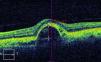

Mujer de 62 años con antecedentes personales de desprendimiento del epitelio pigmentario (DEP) de la retina bilateral, secundario a degeneración macular, que presenta una rotura del mismo en su ojo izquierdo (OI) tras inyección de aflibercept en el ojo contralateral un mes antes.
DiscusiónLa rotura del epitelio pigmentario de la retina (EPR) es la principal complicación cuando se utiliza la terapia anti-VEGF para el manejo de los DEP. Por otro lado, se debe tener en cuenta que la absorción sistémica del fármaco puede inducir algún efecto en el ojo no tratado.
A 62-year-old woman with a history of bilateral retinal pigment epithelium detachment (PED), secondary of age-related macular degeneration (AMD), who presented with a retinal pigment epithelium (RPE) tear on her left eye after an aflibercept injection in the contralateral eye one month earlier.
DiscussionA RPE tear is the main complication when the anti-VEGF therapy is used for the management of the PED. Furthermore, it should be noted that systemic absorption of the drug can induce an effect on the untreated eye.